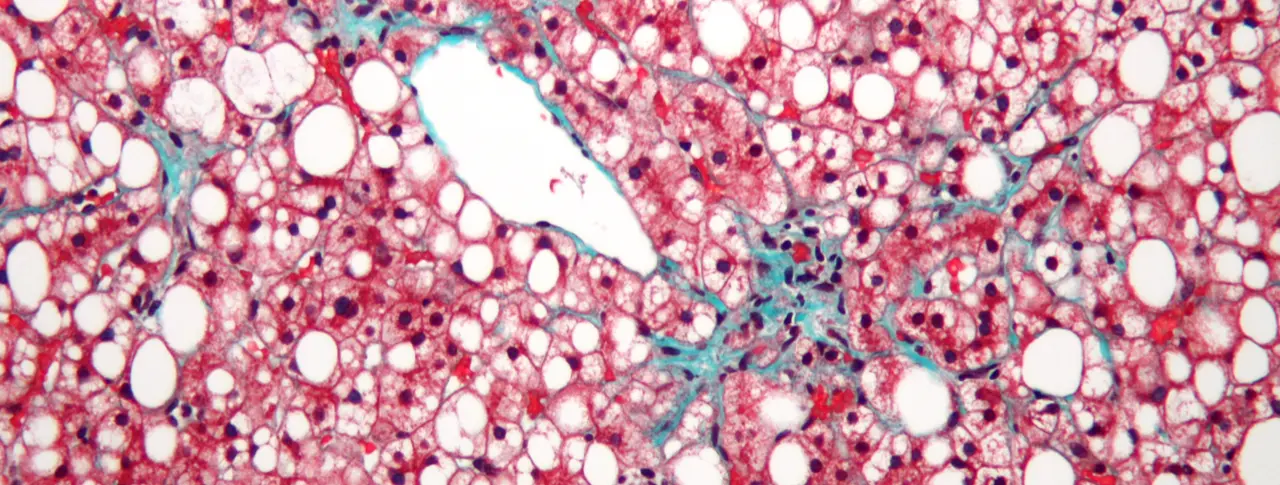
Leveraging the liver’s ability to heal scarred tissue

In medical school, Cliff Brass was interested in the brain. He and a friend, who favored the liver, used to argue about which organ was smarter. They are both hepatologists now.
“I guess that answers that question”, says Brass, Senior Global Program Medical Director at Novartis Pharmaceuticals. “The liver is an amazing organ”.
For instance, it is possible to take a hunk of one person’s liver and transplant it into another person. The partial organ will grow to fit the space available, suggesting that the liver has unusual regenerative capabilities.
It is one thing for a healthy liver to have such powers, but can a scarred liver heal itself? For a long time, the answer was quick and clear: No.
“Despite the fact that evidence of the reversibility of liver scarring started accumulating in the 1960s, the prevailing wisdom was that once you get scar tissue in the liver, it’s permanent”, says Chinwe Ukomadu, a hepatologist and Senior Translational Medicine Specialist at the Novartis Institutes for BioMedical Research.
Only recently have scientists and liver specialists begun to change their answer to a qualified yes. Yes, it’s reversible, but it isn’t clear how. This shift in thinking has opened the door to the idea that medicine may be able to speed up the process. Scarring occurs in many liver diseases and is ultimately the cause of liver failure in late stages of disease, so healing scarred liver tissue would benefit most liver disease patients. For instance, Novartis has recently begun clinical testing of a new investigational compound that might have anti-scarring effects.
One of the first clues suggesting that liver scarring might be reversible came out of a hospital in Miami, FL, in 1962. Doctors there were working with a handful of patients with hemochromatosis, a disorder that causes iron to accumulate in the liver and cause scarring. They took biopsies of patients’ livers before and after performing procedures to remove the iron. After the procedure, they found that the amount of scarring had decreased.
Over time, similar hints appeared in other small-scale studies, says Ukomadu. For instance, the life expectancies of recovering alcoholics—who are thought to have extensive liver scarring—are longer than the life expectancies of people who continue to drink. And patients with autoimmune hepatitis who are treated with steroids to reduce liver damaging inflammation have similar life expectancies whether they begin treatment with advanced liver scarring, called cirrhosis, or without.
“In these cases, something is getting better,” says Ukomadu. “But is it the liver? Researchers have argued that it could be anything”.
The real turning point in thinking came with the advent of treatments for viral liver disease. In the 1990s, drugs became available to treat hepatitis C and hepatitis B. When patients took these drugs, they effectively removed the root cause of the organ damage. Later, liver biopsies revealed that many patients, even those with late-stage cirrhosis had recovered.
“In some cases, you couldn’t tell that the patients had been sick,” says Ukomadu. “Their cirrhosis had completely disappeared”.
Today, researchers at Novartis see two possible ways to repair scarred livers. One is to stop the disease process that is causing the damage and wait for tissue to heal.
This approach has merit, but during the time it takes for the liver to repair itself, patients are left in a vulnerable condition. If they experience another illness or hospitalization while living with an incapacitated liver, they may not fare well. In some cases, this vulnerability may be hidden because patients with liver scarring don’t always show symptoms.
“The liver is a biochemical factory for the body, but it’s a factory with a vast overcapacity”, says Brass. “It may not be until someone’s liver is very close to the edge of keeping up that they suddenly see a dramatic downturn in health”.
Currently the only option for patients with end-stage liver disease is a liver transplant. This procedure is only offered in certain parts of the world, and donor tissue is in short supply.
So Novartis favors a more proactive strategy to find ways to directly reverse scarring to give liver disease patients a fighting chance.
“Many patients who are waiting for transplants become miserably sick,” says Ukomadu. “The ability to stall or reverse liver scarring would have enormous impact”.
Main image: This liver tissue from a patient with non-alcoholic fatty liver disease (NASH) shows mild fibrosis (green), which can lead to advanced liver scarring called cirrhosis. Image: Nephron/Wikimedia
A reversal in thinking about the reversibility of liver damage is changing the field of hepatology.


